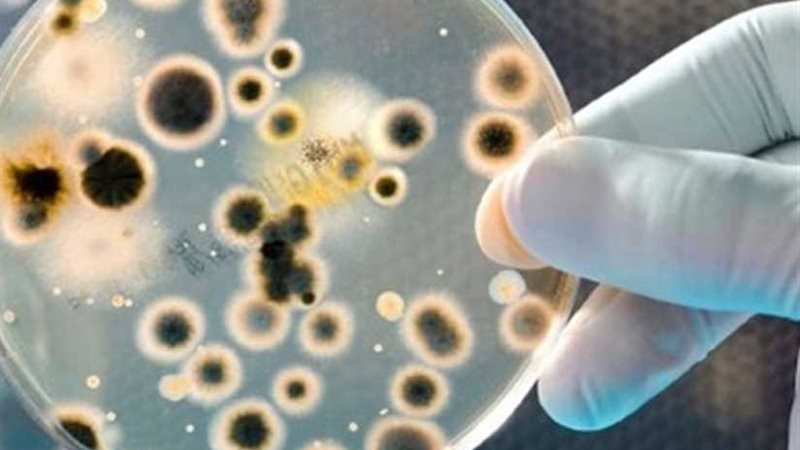
انتشار فيروسات وميكروبات

انتشار فيروسات وميكروبات وبائية مُميتة في الهواء شائعات
كتب - حسن أبو خزيم
انتشر في بعض وسائل الإعلام والمواقع الإلكترونية وصفحات التواصل الاجتماعي أنباء حول انتشار فيروسات وميكروبات وبائية مُميتة في الهواء تهدد حياة المواطنين، وقد قام المركز الإعلامي لمجلس الوزراء بالتواصل مع وزارة الصحة والسكان, والتي نفت تلك الأنباء تمامًا, مُؤكدةً أنه لا صحة لما تردد حول انتشار فيروسات أو ميكروبات وبائية مُميتة في الهواء تهدد حياة المواطنين، وأن كل ما يُثار في هذا الشأن شائعات تستهدف إثارة الخوف والقلق بين المواطنين, مُشددةً على أن مصر خالية تمامًا من أية فيروسات أو ميكروبات وبائية أو غيرها, مُشيرةً إلى أن مصر تُطبق نظام ترصد للأمراض المعدية ذات الأهمية الوبائية، والذي يعد واحداً من أنجح برامج الترصد على مستوى العالم بشهادة المنظمات والجهات الدولية على رأسها منظمة الصحة العالمية.
وأكدت الوزارة على توفيرها فرقاً مُدربة للكشف عن الأمراض والتعامل معها، فضلاً عن التزامها بنظام وقائي متقدم، وتوفيرها جميع الطعوم ضد أي أمراض وبائية محتملة, لافتةً إلى أنها قامت بتشكيل فرق "الاستجابة السريعة" للاستعداد والاستجابة للأحداث الصحية الطارئة، والتفشي الوبائي؛ وذلك لبناء كوادر طبية مُتخصصة على المستوى المركزي وعدد من محافظات الجمهورية، خصوصاً المناطق الحدودية, كما وفرت الوزارة الكميات المطلوبة من الأمصال والطعوم اللازمة لمواجهة أي أمراض وقائية طارئة في أي محافظة بالجمهورية حال حدوثها, مُضيفةً أنه تم إنشاء برنامج إلكتروني جديد يهدف إلى ربط بيانات القادمين من الدول بمنافذ الحجر الصحي مباشرةً بالخط الساخن "105"، بهدف متابعة الحالة الصحية للقادمين لضمان عدم انتقال أي أمراض وافدة من الدول التي بها تفشي وبائي.
وفي سياق متصل, أشارت الوزارة إلى أنه في إطار حرصها على الصحة الوقائية للمواطنين, إلى جانب تقديم الخدمات الطبية المجانية لهم في المناطق النائية والمحرومة من الخدمات الصحية, قامت الوزارة بإطلاق 103 قوافل طبية مجانية بدءاً من 31 مارس وحتى يوم 10 أبريل الماضي بـ21 محافظة, حيث تم توقيع الكشف الطبي وتقديم العلاج بالمجان لـ119 ألفاً و805 مواطنين, بالإضافة إلى إجراء 17 ألفاً و576 تحليل دم وطفيليات وأشعة، وعقد 28 ألفاً و490 ندوة تثقيف صحي لرفع الوعي الصحي لدى المواطنين، لافتةً إلى أنه تم تحويل 1595حالة إلى المستشفيات لإجراء عمليات جراحية واستصدار قرارات من المجالس الطبية للعلاج على نفقة الدولة والتأمين الصحي.
وفي النهاية، ناشدت الوزارة وسائل الإعلام المختلفة ومرتادي مواقع التواصل الاجتماعي تحري الدقة والموضوعية في نشر الأخبار والتواصل مع الجهات المعنية بالوزارة للتأكد قبل نشر معلومات لا تستند إلى أي حقائق، وتؤدي إلى إثارة الخوف والقلق بين المواطنين، وللتحقق من أي معلومات أو أخبار متداولة حول هذا الشأن يمكن الاتصال على رقم الوزارة (25354150/02).







